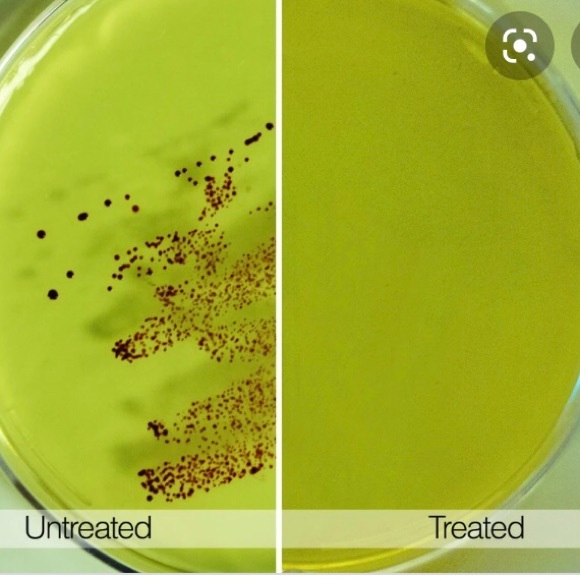
Tech Candy UV Sanitizer - Picture 3 of 6

Tech Candy UV Sanitizer
C$20 C$60
Size
Like and save for later
Add To Bundle
This portable sanitizer kills 99.9% of Staph, E.Coli, Salmonella and other harmful bacteria on hard surfaces in minutes using UV-C technology (same as used in self-cleaning water bottles). Great for cleaning phones, keys and other items. Takes 4 AA batteries (included).
Only used once of twice (I just didn’t end up needing it, I already had something similar).
Shipping/Discount

visualeyecandy
likes this
Trending Now
Find Similar Listings
Account is under Review
Comment posting is temporarily restricted. Our team will reach out to you shortly. To understand why, select
Learn More.